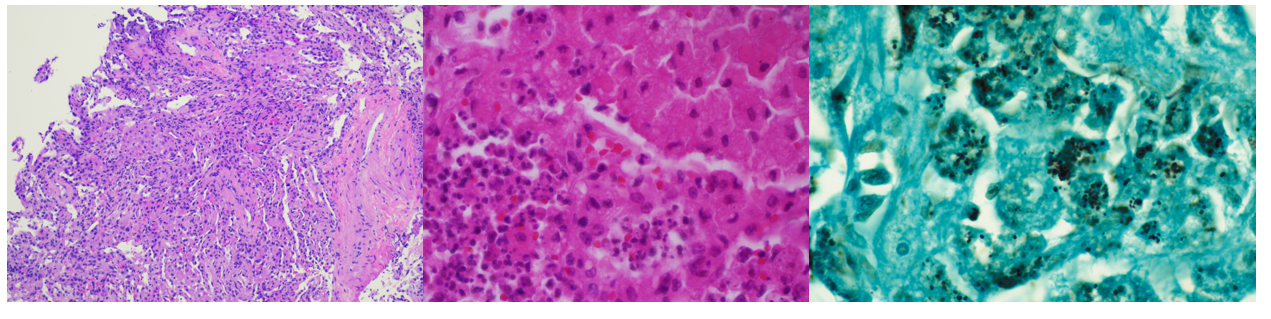

Case History
A 46 year old male with a history of cystic fibrosis and bilateral lung transplant two years prior presented to the hospital with chest pain and hemoptysis. The patient was recently diagnosed with COVID-19, and a CT chest revealed multiple rounded, mass-like opacities with central cavitation. As imaging was not consistent with COVID-19 pulmonary disease and no clear risk for tuberculosis could be identified, a bronchoscopy with transbronchial biopsy was performed. Tissue and bronchiolar lavage fluid were collected and submitted to the microbiology laboratory for analysis. Viral etiologies including influenza A/B, Parainfluenza 1-3, Adenovirus, RSV and metapneumovirus were ruled out through molecular studies. Galactomannan was negative from the BAL fluid, as were fungal and mycobacterial cultures and Mycobacterium tuberculosis PCR. GMS staining of the biopsy was negative but organizing pneumonia and mononuclear infiltrate was noted. The patient had a history of recurrent multidrug-resistant Pseudomonas aeruginosa infection and was being managed with empiric ceftazidime/avibactam.
Laboratory Identification
Gram stains of both the tissue and BAL fluid were generally unremarkable. Histopathological analysis of the transbronchial tissue revealed changes suggestive of organizing pneumonia with mononuclear infiltrate (Image 2, left). Bacterial growth of a predominant organism from both the BAL and biopsy tissue was observed on plates after 48 hours on blood and chocolate agars but was absent on MacConkey agar. At 96 hours, the colonies of the organism had become mucoid, slightly pink and had coalesced (Image 1, right). Gram staining of the growth revealed short, poorly staining gram positive coccobacilli with a beaded appearance. Due to the incomplete gram staining of this isolate, modified acid-fast staining was attempted which was positive (Image 1, left). The organism was both catalase- and urease-positive. The isolate was subsequently identified by MALDI-TOF MS as Rhodococcus equi, and the patient was discharged from the hospital on imipenem and linezolid.

Discussion
Rhodococcus equi is a zoonotic pathogen which primarily causes infections among immunocompromised hosts. Infrequently isolated clinically, the organism is a primary pathogen of horses causing pneumonia with abscess formation in foals, often with dissemination into peripheral sites due to high organism burden. The organism is excreted in feces of infected animals, leading to contamination of soils from farms, ranches, and other agricultural environments from which the organism is either aerosolized and inhaled or acquired via direct inoculation.1 While human infections are classically associated with exposure to horses or their environment, there is a growing body of literature to suggest that many patients with microbiologically proven cases of R. equi infection lack such environmental exposures. This patient falls into the latter category, with no known exposure to livestock.
R. equi is a member of the aerobic actinomycetes. Like Nocardia sp., the cell wall of R. equi contains mycolic acids which lead to positivity when stained with a modified acid-fast stain. The organism is a facultative, intracellular pathogen surviving within macrophages and histiocytes, leading to granulomatous inflammation, eventually leading to necrosis.2 Immunosuppression (including HIV infection or immunosuppressive therapy) is a major risk factor for R. equi infection, as most clinical cases are reported in this setting. In immunocompromised hosts, the spectrum of disease manifestations of R. equi are diverse, but most commonly (approx. 80%) include pulmonary involvement3 with upper lobe cavitary pneumonia.4 Characteristic malakoplakia (an infiltration of foamy histocytes with intracellular bacteria and basophilic inclusions name Michaelis-Gutmann bodies)1 can be associated with R. equi infection. These structures were noticeably absent in this patient’s case despite the observed histocyte aggregation and mononuclear infiltrate (Image 2, center, left).
R. equi pneumonia among solid organ transplant recipients, such as the patient in this case is associated with low overall morbidity and mortality, but require protracted antibiotic therapy regimens.1 Susceptibility testing is warranted to guide therapy of R. equi due to unpredictable resistance patterns among isolates. This patient’s isolate was revealed to be susceptible to amoxicillin/clavulanate, ceftriaxone, imipenem, ciprofloxacin, moxifloxacin, clarithromycin, amikacin, tobramycin, minocycline, trimethoprim/sulfamethoxazole, vancomycin, linezolid, and rifampin. The patient was discharged on imipenem/linezolid. At follow-up, the patient had clinically improved with a resolution of symptoms, but his radiologic abnormalities persisted and thus remains on oral therapy with moxifloxacin and minocycline.
References
Yamshchikov, AV, Schuetz, A, and Lyon, GM. Rhodococcus equi infection. 2010. Lancet Infect. Dis. 10:350-359.
Prescott, JF. Rhodococcus equi: an Animal and Human Pathogen. 1991. Clin. Microbiol. Rev. 4(1):20-34.
Weinstock, DM, and Brown, AE. Rhodococcus equi: an emerging pathogen. 2002. Clin. Infect. Dis. 34:1379-1385.
Mutaner, L, et. al. Radiologic featuresof Rhodococcus equi pneumonia in AIDS. Eur. J. Radiology. 1997. 66-70.

-Andrew Clark, PhD, D(ABMM) is an Assistant Professor at UT Southwestern Medical Center in the Department of Pathology, and Associate Director of the Clements University Hospital microbiology laboratory. He completed a CPEP-accredited postdoctoral fellowship in Medical and Public Health Microbiology at National Institutes of Health, and is interested in antimicrobial susceptibility and anaerobe pathophysiology.
-Dominick Cavuoti is a Professor in the Department of Pathology at UT Southwestern Medical Center. Dr. Cavuoti is a board certified AP/CP who is a practicing Clinical Microbiologist, Infectious Disease pathologist and Cytopathologist.

-Clare McCormick-Baw, MD, PhD is an Assistant Professor of Clinical Microbiology at UT Southwestern in Dallas, Texas. She has a passion for teaching about laboratory medicine in general and the best uses of the microbiology lab in particular.